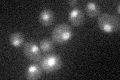
YKL074C
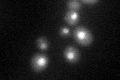
YKL074C
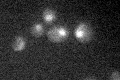
YKL074C
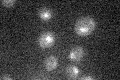
YKL074C

View description
Protein involved in early pre-mRNA splicing; component of the pre-mRNA-U1 snRNP complex, the commitment complex; interacts with Msl5p/BBP splicing factor and Sub2p; similar to metazoan splicing factor U2AF65
Localization:
Intensity:
Fold change:
Significance:
-
C’ GFP library in SD
nucleus22.74 -
N' NOP1pr-GFP in SD

N/A0 -
N' TEF2pr-mCherry in SD

N/A0 -
N' NATIVEpr-GFP in SD

N/A0 -
N' TEF2pr-VC and Cyto-VN in SD

N/A0 -
C’ GFP library in SD+DTT
nucleus28.021.23No -
C’ GFP library in SD+H2O2
nucleus20.110.88No -
C’ GFP library in Starvation Media
nucleus17.140.75Yes -
C’ GFP library on the background of Pup2-DaMP

nucleus -
C’ GFP library on the background of CCT mutant

nucleus31.1041.36755No
